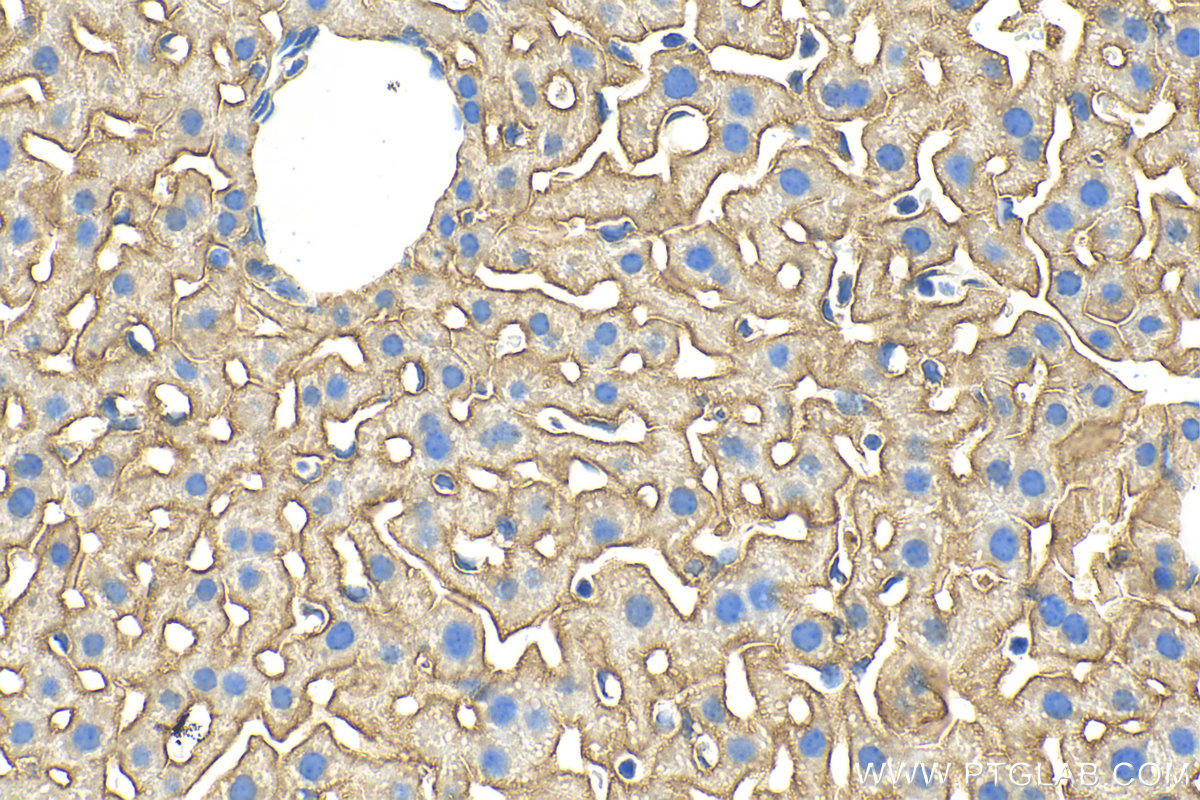

验证数据展示
经过测试的应用
| Positive WB detected in | mouse heart tissue, mouse spleen tissue, rat heart tissue |
| Positive IHC detected in | mouse liver tissue Note: suggested antigen retrieval with TE buffer pH 9.0; (*) Alternatively, antigen retrieval may be performed with citrate buffer pH 6.0 |
| Positive IF/ICC detected in | U2OS cells |
推荐稀释比
| 应用 | 推荐稀释比 |
|---|---|
| Western Blot (WB) | WB : 1:1000-1:4000 |
| Immunohistochemistry (IHC) | IHC : 1:50-1:500 |
| Immunofluorescence (IF)/ICC | IF/ICC : 1:200-1:800 |
| It is recommended that this reagent should be titrated in each testing system to obtain optimal results. | |
| Sample-dependent, Check data in validation data gallery. | |
发表文章中的应用
| WB | See 4 publications below |
| IHC | See 3 publications below |
产品信息
26540-1-AP targets SLC39A14/ZIP-14 in WB, IHC, IF/ICC, ELISA applications and shows reactivity with human, mouse, rat samples.
| 经测试应用 | WB, IHC, IF/ICC, ELISA Application Description |
| 文献引用应用 | WB, IHC |
| 经测试反应性 | human, mouse, rat |
| 文献引用反应性 | human, mouse |
| 免疫原 |
CatNo: Ag24210 Product name: Recombinant human SLC39A14 protein Source: e coli.-derived, PGEX-4T Tag: GST Domain: 34-152 aa of BC015770 Sequence: GAPAISAASFLQDLIHRYGEGDSLTLQQLKALLNHLDVGVGRGNVTQHVQGHRNLSTCFSSGDLFTAHNFSEQSRIGSSELQEFCPTILQQLDSRACTSENQENEENEQTEEGRPSAVE 种属同源性预测 |
| 宿主/亚型 | Rabbit / IgG |
| 抗体类别 | Polyclonal |
| 产品类型 | Antibody |
| 全称 | solute carrier family 39 (zinc transporter), member 14 |
| 别名 | cig19, KIAA0062, LZT Hs4, SLC39A14, Zinc transporter ZIP14, ZIP 14, ZIP14, Zrt and Irt like protein 14 |
| 计算分子量 | 54 kDa |
| 观测分子量 | 54 kDa |
| GenBank蛋白编号 | BC015770 |
| 基因名称 | SLC39A14/ZIP-14 |
| Gene ID (NCBI) | 23516 |
| RRID | AB_3085879 |
| 偶联类型 | Unconjugated |
| 形式 | Liquid |
| 纯化方式 | Antigen affinity purification |
| UNIPROT ID | Q15043 |
| 储存缓冲液 | PBS with 0.02% sodium azide and 50% glycerol, pH 7.3. |
| 储存条件 | Store at -20°C. Stable for one year after shipment. Aliquoting is unnecessary for -20oC storage. |
背景介绍
Metal cation symporter ZIP14 (SLC39A14) is an electroneutral transporter of the plasma membrane that mediates the cellular uptake of divalent metal cations zinc, manganese, and iron and is important for tissue homeostasis, metabolism, development and immunity (PubMed:15642354, PubMed:27231142, PubMed:29621230). The molecular weight is around 53-54 kDa.
实验方案
| Product Specific Protocols | |
|---|---|
| IF protocol for SLC39A14/ZIP-14 antibody 26540-1-AP | Download protocol |
| IHC protocol for SLC39A14/ZIP-14 antibody 26540-1-AP | Download protocol |
| WB protocol for SLC39A14/ZIP-14 antibody 26540-1-AP | Download protocol |
| Standard Protocols | |
|---|---|
| Click here to view our Standard Protocols |
发表文章
| Species | Application | Title |
|---|---|---|
Front Mol Biosci Single-cell transcriptomics uncover the key ferroptosis regulators contribute to cancer progression in head and neck squamous cell carcinoma | ||
Arthritis Res Ther Identification and verification of a novel signature that combines cuproptosis-related genes with ferroptosis-related genes in osteoarthritis using bioinformatics analysis and experimental validation | ||
Adv Sci (Weinh) Creatine Promotes Endometriosis by Inducing Ferroptosis Resistance via Suppression of PrP | ||
Cell Signal Elucidating ferroptosis mechanisms in heart failure through transcriptomics, single-cell sequencing, and experimental validation | ||
Free Radic Biol Med Ferredoxin 1-like maintains iron homeostasis and hepatoma cell survival | ||
JCI Insight NSD1-916aa encoded by CircNSD1 contributes to AKI-to-CKD transition through inducing ferroptosis in tubular epithelial cells |